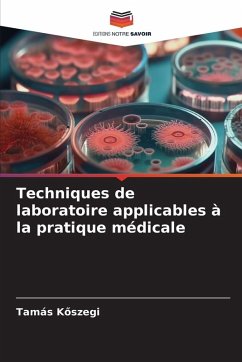
Cover Techniques de laboratoire applicables à la pratique médicale

La maladie de Behçet, ce n'est pas qu'une question de tests de laboratoire
Versandkostenfrei!
Versandfertig in 6-10 Tagen
26,99 €
inkl. MwSt.

PAYBACK Punkte
13 °P sammeln!
Le syndrome de Behcet est une maladie inflammatoire chronique et multisystémique d'origine inconnue. Le syndrome se caractérise par des ulcères buccaux et génitaux récurrents, des lésions oculaires et cutanées, de l'arthrite, des troubles du système nerveux central et des maladies vasculaires. Les ulcérations buccales récurrentes sont considérées comme l'une des manifestations les plus importantes du syndrome et sont au coeur du diagnostic selon les critères de classification. Un cas clinique est présenté dans lequel la patiente cherche à se faire soigner pour ses lésions apht...
Le syndrome de Behcet est une maladie inflammatoire chronique et multisystémique d'origine inconnue. Le syndrome se caractérise par des ulcères buccaux et génitaux récurrents, des lésions oculaires et cutanées, de l'arthrite, des troubles du système nerveux central et des maladies vasculaires. Les ulcérations buccales récurrentes sont considérées comme l'une des manifestations les plus importantes du syndrome et sont au coeur du diagnostic selon les critères de classification. Un cas clinique est présenté dans lequel la patiente cherche à se faire soigner pour ses lésions aphteuses récurrentes et, grâce à une prise en charge multidisciplinaire, le diagnostic est posé.